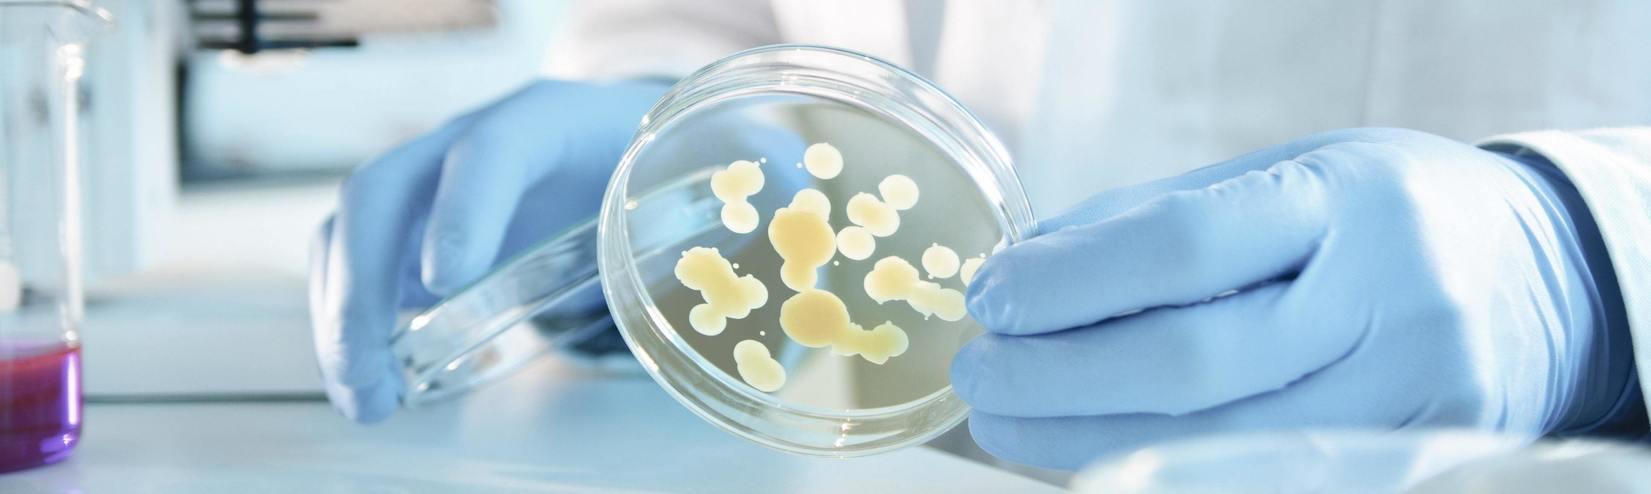

Microbiology
Microbiology testing plays a crucial role in the detection and monitoring of infectious diseases, supporting accurate diagnosis and effective patient management. Reliable laboratory assays are essential to identify pathogens and evaluate immune responses across a wide range of clinical applications.
From infectious serology to specialized culture media and cell-based systems, well-standardized and high-quality solutions ensure consistent and reproducible results. Automated and ready-to-use formats further support laboratories in optimizing workflow efficiency and maintaining high diagnostic standards.
Our microbiology portfolio offers a comprehensive range of solutions, enabling laboratories to perform routine and specialized testing with confidence.
Trusted serology for confident infectious disease diagnosis

Virology / Bacteriology / Parasites
- target values proposed specifically for Phadia instruments.
- liquid and to be used as a patient sample
- autoimmune antibodies per disease, all isotypes included, as well as allergy markers, tryptase and fecal calprotectin
- PATHQAS program with peer to peer group analysis available

Fungi-Line
- target values proposed specifically for Phadia instruments.
- liquid and to be used as a patient sample
- autoimmune antibodies per disease, all isotypes included, as well as allergy markers, tryptase and fecal calprotectin
- PATHQAS program with peer to peer group analysis available

Autodat
- target values proposed specifically for Phadia instruments.
- liquid and to be used as a patient sample
- autoimmune antibodies per disease, all isotypes included, as well as allergy markers, tryptase and fecal calprotectin
- PATHQAS program with peer to peer group analysis available

Cell-Line
- target values proposed specifically for Phadia instruments.
- liquid and to be used as a patient sample
- autoimmune antibodies per disease, all isotypes included, as well as allergy markers, tryptase and fecal calprotectin
- PATHQAS program with peer to peer group analysis available